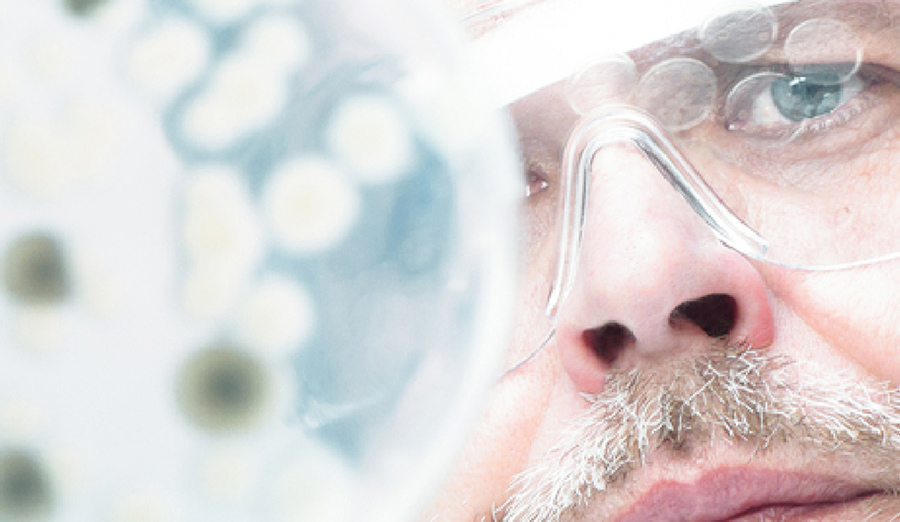
Laboratory researcher in ppe looking at petri dish

Research Opportunities & Educational Grants
Research opportunities and educational grants
As part of our mission to manage complexity and improve lives, we at Mallinckrodt are committed to supporting research as well as educational programming to accelerate diagnosis and treatment in a variety of therapeutic areas.

The ECP Immunomodulation investigator award
Investigator-initiated research
The mission of the Investigator Initiated Research (IIR) Programme is to improve the lives of our patients by increasing the medical and scientific understanding of our products and related therapeutic areas.

Independent Medical Education Grants
We are committed to supporting independent, high-quality educational programmes for healthcare professionals.

Medical Writing Grants
We strive to help improve the lives of patients by increasing the medical and scientific understanding of our products and related therapeutic areas.



